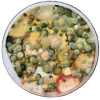
Emoji

плесень и липовый мёд
Статичные Emoji Telegram «плесень и липовый мёд» (ID: strangestuff_cvetgranata_by_TgEmodziBot). С момента загрузки их посмотрели 102 раз, установили 22 раз. Набор содержит 66 эмодзи.
Добавить в TelegramВсе эмодзи:

🤩

🤩

🤩

🤩

🤩

🤩

🤩

🤩

🤩

🤩

🤩

🤩

🤩

🤩

🤩

🤩

🤩

🤩

🤩

🤩

🤩
🤩

🤩

🤩

🤩

🤩

🤩

🤩

🤩

🤩

🤩

🤩

🤩

🤩

🤩

🤩

🤩

🤩

🤩

🤩

🤩

🤩

🤩

🤩

🤩

🤩

🤩

🤩

🤩

🤩

🤩

🤩

🤩

🤩

🤩

🤩

🤩

🤩

🤩

🤩

🤩

🤩

🤩

🤩

🤩

🤩